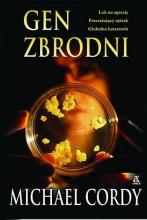

á
â
ă
ä
ç
č
ď
đ
é
ë
ě
í
î
ľ
ĺ
ň
ô
ő
ö
ŕ
ř
ş
š
ţ
ť
ů
ú
ű
ü
ý
ž
®
€
ß
Á
Â
Ă
Ä
Ç
Č
Ď
Đ
É
Ë
Ě
Í
Î
Ľ
Ĺ
Ň
Ô
Ő
Ö
Ŕ
Ř
Ş
Š
Ţ
Ť
Ů
Ú
Ű
Ü
Ý
Ž
©
§
µ